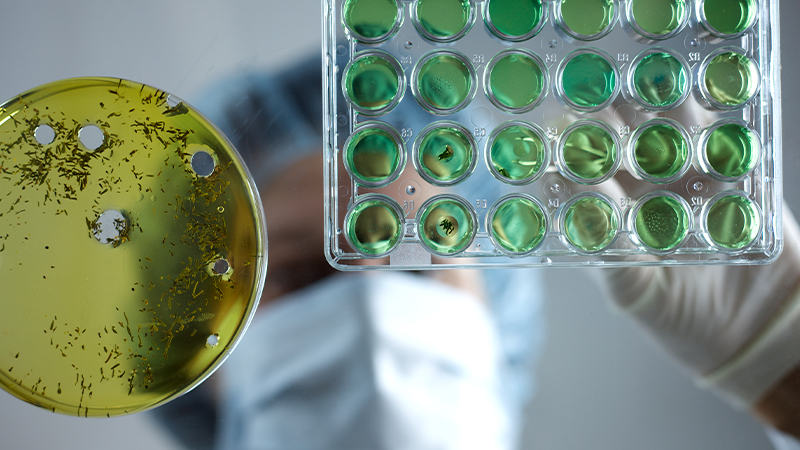
Category Image

CALA Training
Empowering Laboratories Through Education
Your Partner in Accreditation Excellence
At CALA Training, we lead the way in accreditation-focused education for laboratories. We help individuals and organizations develop the skills and knowledge required to meet the requirements of ISO/IEC 17025. Choose from instructor-led courses, interactive webinars, self-paced e-learning, or customized private training tailored to your organization’s needs. Every course is developed and delivered by experienced laboratory professionals—including experts with extensive experience assessing laboratories—so you gain practical insights that make a real impact.
Start your journey to accreditation success today-explore our courses and take the next step towards excellence.